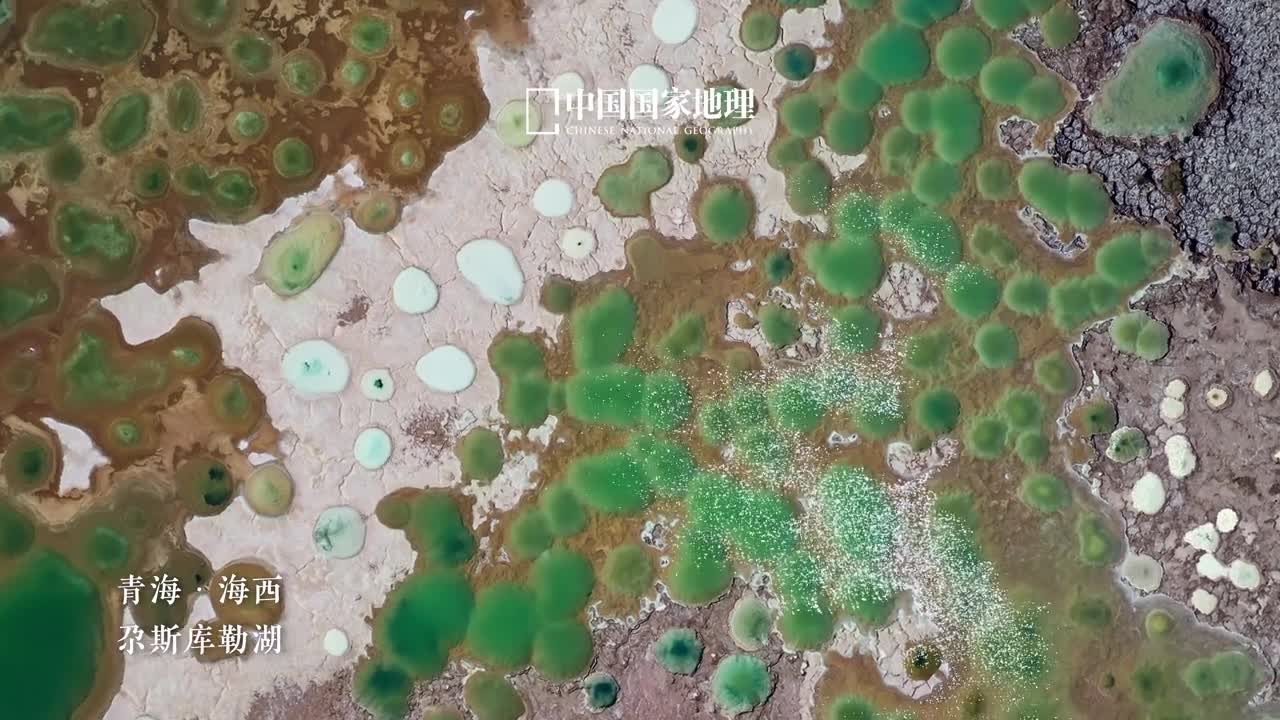
走进自然奇观的魔幻之境造型奇异的风蚀雅丹瑰丽壮美的丹霞地貌危峰耸峙的断壁深峡在大地之上演绎世间万象铺展锦绣华章置身其间仿佛能在这静默的自然景观中窥见亿万年地貌演化的沧桑

-
 辛苦了让赛里木湖的冰推抚慰你吧冰湖微澜碎冰闪烁赛里木湖的冰推景观是大自然给予人间的极致浪漫在冰推柔和的白噪音中放松一下吧卸下繁重思绪感受世间的平静与美好
辛苦了让赛里木湖的冰推抚慰你吧冰湖微澜碎冰闪烁赛里木湖的冰推景观是大自然给予人间的极致浪漫在冰推柔和的白噪音中放松一下吧卸下繁重思绪感受世间的平静与美好 -
 辈是场修短的是旅长的是
辈是场修短的是旅长的是 -
 车在路上走人在画中游在四川省阿坝州壤塘县有一条路景融合的壮美公路西起上杜柯东入南木达这条千回百转的尚蓝天路又名上南天路成为壤塘县旅游的一张靓丽名片
车在路上走人在画中游在四川省阿坝州壤塘县有一条路景融合的壮美公路西起上杜柯东入南木达这条千回百转的尚蓝天路又名上南天路成为壤塘县旅游的一张靓丽名片 -
 踏上331国道开启秋日赏林之旅
踏上331国道开启秋日赏林之旅 -
 路过的是风景留下的才是人生
路过的是风景留下的才是人生 -
 跨越千年的天下名关甘肃酒泉的戈壁滩辽阔旷远大名鼎鼎的玉门关屹立于此放眼望去烽燧和残垣断续延绵诠释着春风不度玉门关的孤寂壮美
跨越千年的天下名关甘肃酒泉的戈壁滩辽阔旷远大名鼎鼎的玉门关屹立于此放眼望去烽燧和残垣断续延绵诠释着春风不度玉门关的孤寂壮美 -
 跟随小溪来一场山野探险之旅清溪奔快不管青山碍走进森野密丛聆听溪水叮咚夏日明快的节拍总是鲜活惹人爱好想赤裸着双足踩进清冽的溪流彻底放空身心做个自在闲人
跟随小溪来一场山野探险之旅清溪奔快不管青山碍走进森野密丛聆听溪水叮咚夏日明快的节拍总是鲜活惹人爱好想赤裸着双足踩进清冽的溪流彻底放空身心做个自在闲人 -
 跟着地理君抵达最欢乐的闹元宵现场元宵节是共乐太平的灯辉绮节是中国百姓的盛大嘉年华邀你来中国国家地理的直播间一起共享月圆之夜的视觉盛宴福建莆田广东梅州广东佛山海南海口等地的非遗表演民俗活动烟火盛会将轮番上演地理君带大家一起从多角度多方位寻找最佳观赏点共享佳节的绚烂与浪漫明天2月12日1900来中国国家地理的直播间我们不见不散
跟着地理君抵达最欢乐的闹元宵现场元宵节是共乐太平的灯辉绮节是中国百姓的盛大嘉年华邀你来中国国家地理的直播间一起共享月圆之夜的视觉盛宴福建莆田广东梅州广东佛山海南海口等地的非遗表演民俗活动烟火盛会将轮番上演地理君带大家一起从多角度多方位寻找最佳观赏点共享佳节的绚烂与浪漫明天2月12日1900来中国国家地理的直播间我们不见不散 -
 越过山丘会发现还有山丘古日格斯台国家级自然保护区位于大兴安岭南部山地余脉西麓这里的山坡连绵不绝随性起伏点缀着点点绿树
越过山丘会发现还有山丘古日格斯台国家级自然保护区位于大兴安岭南部山地余脉西麓这里的山坡连绵不绝随性起伏点缀着点点绿树 -
 超越未见只因热爱新的一周新的开始
超越未见只因热爱新的一周新的开始 -
 赴一场高山上的春茶之旅鹿鸣茶海位于四川宜宾的川云山巅这里是久负盛名的鹿鸣贡茶的出产地茶山高地空气氤氲溪涧纵横有着诗经中呦呦鹿鸣般的清幽之美
赴一场高山上的春茶之旅鹿鸣茶海位于四川宜宾的川云山巅这里是久负盛名的鹿鸣贡茶的出产地茶山高地空气氤氲溪涧纵横有着诗经中呦呦鹿鸣般的清幽之美 -
走进自然奇观的魔幻之境造型奇异的风蚀雅丹瑰丽壮美的丹霞地貌危峰耸峙的断壁深峡在大地之上演绎世间万象铺展锦绣华章置身其间仿佛能在这静默的自然景观中窥见亿万年地貌演化的沧桑
走进自然奇观的魔幻之境造型奇异的风蚀雅丹瑰丽壮美的丹霞地貌危峰耸峙的断壁深峡在大地之上演绎世间万象铺展锦绣华章置身其间仿佛能在这静默的自然景观中窥见亿万年地貌演化的沧桑 -
 走进自然去露营让山河入梦来久居城市的你是否向往这样的体验眼前是天空与碧草耳边是鸟啼虫鸣大自然的气息扑面而来这些天然的景色和声音都会放松我们的心情缓解焦虑在评论区聊聊你的露营体验吧
走进自然去露营让山河入梦来久居城市的你是否向往这样的体验眼前是天空与碧草耳边是鸟啼虫鸣大自然的气息扑面而来这些天然的景色和声音都会放松我们的心情缓解焦虑在评论区聊聊你的露营体验吧 -
 走进现实中的奇幻美景在新疆阿克苏的库车大峡谷红色岩层被大自然雕刻成数不清的天然雕塑宛如奇幻大片里的场景峡谷中光影变幻壮美之中又透着令人着迷的神秘感
走进现实中的奇幻美景在新疆阿克苏的库车大峡谷红色岩层被大自然雕刻成数不清的天然雕塑宛如奇幻大片里的场景峡谷中光影变幻壮美之中又透着令人着迷的神秘感 -
 走进惊艳时光的斑斓秘境阿什贡位于青海贵德国家地质公园内宛如一幅缤纷多彩的画卷徐徐展开在世人面前在这里丹霞黄河蓝天白云与绿树交相辉映演绎着大自然的绮丽多姿特别是那层次分明的红色岩层仿佛是大地的血脉见证着岁月的变迁
走进惊艳时光的斑斓秘境阿什贡位于青海贵德国家地质公园内宛如一幅缤纷多彩的画卷徐徐展开在世人面前在这里丹霞黄河蓝天白云与绿树交相辉映演绎着大自然的绮丽多姿特别是那层次分明的红色岩层仿佛是大地的血脉见证着岁月的变迁 -
 走进山间感受春天的气息春水动春山明碧溪翠林深邃幽渺此刻湖北恩施五龙山明媚而又富有生机走进五龙山仿佛踏入了与世隔绝的仙境蜿蜒的山道盘旋而上沿途树木参天枝繁叶茂微风中有阵阵清香让人沉醉
走进山间感受春天的气息春水动春山明碧溪翠林深邃幽渺此刻湖北恩施五龙山明媚而又富有生机走进五龙山仿佛踏入了与世隔绝的仙境蜿蜒的山道盘旋而上沿途树木参天枝繁叶茂微风中有阵阵清香让人沉醉 -
 走进大瓦山的奇景世界位于四川乐山的大瓦山山顶平坦如桌是典型的桌状山这里三面绝壁雄伟而奇特当你在不同的时段欣赏大瓦山会发现不一样的美无论是霞光之下的明艳动人还是云海之中的灵秀清丽都令人无限向往
走进大瓦山的奇景世界位于四川乐山的大瓦山山顶平坦如桌是典型的桌状山这里三面绝壁雄伟而奇特当你在不同的时段欣赏大瓦山会发现不一样的美无论是霞光之下的明艳动人还是云海之中的灵秀清丽都令人无限向往 -
 走一起去禾木村撒个野邂逅零下35度的冰雪王国
走一起去禾木村撒个野邂逅零下35度的冰雪王国 -
 赤甲白盐俱刺天置身于三峡之巅的重庆奉节长江北岸赤甲山顶可将瞿塘峡两岸风光尽收眼底
赤甲白盐俱刺天置身于三峡之巅的重庆奉节长江北岸赤甲山顶可将瞿塘峡两岸风光尽收眼底 -
 赠你纳木错的一川风月一年倏忽又至尾声疾步前行的人们啊有多久没有停下脚步用心感受世间的美好这世界山川湖海都温柔这人间风花雪月都浪漫放下繁事杂念到大自然的怀抱中去人间值得一游
赠你纳木错的一川风月一年倏忽又至尾声疾步前行的人们啊有多久没有停下脚步用心感受世间的美好这世界山川湖海都温柔这人间风花雪月都浪漫放下繁事杂念到大自然的怀抱中去人间值得一游 -
 赛里木湖的冬日浪漫千里冰封天空之镜映照苍穹
赛里木湖的冬日浪漫千里冰封天空之镜映照苍穹 -
 赛里木湖新疆的海
赛里木湖新疆的海 -
 赛里木湖又到了每年的冰封季湖里都会出现这种独特冰推奇观在远处雪山的映衬下恍若进入了冰雪奇缘般的梦境
赛里木湖又到了每年的冰封季湖里都会出现这种独特冰推奇观在远处雪山的映衬下恍若进入了冰雪奇缘般的梦境 -
 赛里木湖冰推治愈一切不开心每年湖冰消融之际新疆博州赛里木湖的冰推都将为人间带来一场治愈的自然交响在恰到好处的温度之下湖面似冻非冻似融非融碎钻般的冰块跟随风和水的脚步时聚时散叮咚作响值此春深夏浅好时节来赛里木湖感受纯粹的自然白噪音吧
赛里木湖冰推治愈一切不开心每年湖冰消融之际新疆博州赛里木湖的冰推都将为人间带来一场治愈的自然交响在恰到好处的温度之下湖面似冻非冻似融非融碎钻般的冰块跟随风和水的脚步时聚时散叮咚作响值此春深夏浅好时节来赛里木湖感受纯粹的自然白噪音吧











